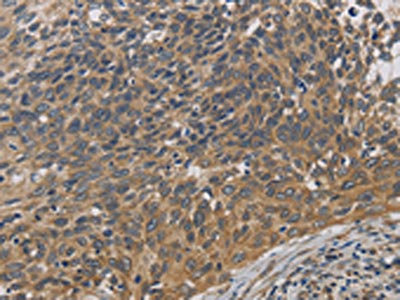

EMC8 Antibody
-
中文名稱:EMC8兔多克隆抗體
-
貨號(hào):CSB-PA276232
-
規(guī)格:¥1100
-
圖片:
-
The image on the left is immunohistochemistry of paraffin-embedded Human liver cancer tissue using CSB-PA276232(EMC8 Antibody) at dilution 1/30, on the right is treated with fusion protein. (Original magnification: ×200)
-
The image on the left is immunohistochemistry of paraffin-embedded Human cervical cancer tissue using CSB-PA276232(EMC8 Antibody) at dilution 1/30, on the right is treated with fusion protein. (Original magnification: ×200)
-
Gel: 10%SDS-PAGE, Lysate: 40 μg, Lane 1-3: A549 cells, Hela cells, HT29 cells, Primary antibody: CSB-PA276232(EMC8 Antibody) at dilution 1/600, Secondary antibody: Goat anti rabbit IgG at 1/8000 dilution, Exposure time: 1 minute
-
-
其他:
產(chǎn)品詳情
-
Uniprot No.:
-
基因名:EMC8
-
別名:C16orf2 antibody; C16orf4 antibody; COX4 neighbor antibody; COX4; neighbor of antibody; COX4AL antibody; Cox4nb antibody; CX4NB_HUMAN antibody; ER membrane protein complex subunit 8 antibody; FAM158B antibody; family with sequence similarity 158; member B antibody; Neighbor of COX4 antibody; NOC4 antibody; Protein FAM158B antibody
-
宿主:Rabbit
-
反應(yīng)種屬:Human,Mouse,Rat
-
免疫原:Fusion protein of Human EMC8
-
免疫原種屬:Homo sapiens (Human)
-
標(biāo)記方式:Non-conjugated
-
抗體亞型:IgG
-
純化方式:Antigen affinity purification
-
濃度:It differs from different batches. Please contact us to confirm it.
-
保存緩沖液:-20°C, pH7.4 PBS, 0.05% NaN3, 40% Glycerol
-
產(chǎn)品提供形式:Liquid
-
應(yīng)用范圍:ELISA,WB,IHC
-
推薦稀釋比:
Application Recommended Dilution ELISA 1:2000-1:5000 WB 1:500-1:2000 IHC 1:50-1:200 -
Protocols:
-
儲(chǔ)存條件:Upon receipt, store at -20°C or -80°C. Avoid repeated freeze.
-
貨期:Basically, we can dispatch the products out in 1-3 working days after receiving your orders. Delivery time maybe differs from different purchasing way or location, please kindly consult your local distributors for specific delivery time.
-
用途:For Research Use Only. Not for use in diagnostic or therapeutic procedures.
相關(guān)產(chǎn)品
靶點(diǎn)詳情
-
功能:Part of the endoplasmic reticulum membrane protein complex (EMC) that enables the energy-independent insertion into endoplasmic reticulum membranes of newly synthesized membrane proteins. Preferentially accommodates proteins with transmembrane domains that are weakly hydrophobic or contain destabilizing features such as charged and aromatic residues. Involved in the cotranslational insertion of multi-pass membrane proteins in which stop-transfer membrane-anchor sequences become ER membrane spanning helices. It is also required for the post-translational insertion of tail-anchored/TA proteins in endoplasmic reticulum membranes. By mediating the proper cotranslational insertion of N-terminal transmembrane domains in an N-exo topology, with translocated N-terminus in the lumen of the ER, controls the topology of multi-pass membrane proteins like the G protein-coupled receptors. By regulating the insertion of various proteins in membranes, it is indirectly involved in many cellular processes (Probable).
-
亞細(xì)胞定位:Endoplasmic reticulum membrane; Peripheral membrane protein; Cytoplasmic side.
-
蛋白家族:EMC8/EMC9 family
-
組織特異性:Expressed in liver, pancreas, heart, lung, kidney, brain, skeletal muscle, and placenta. Expression levels are highest in pancreas and moderate in heart, skeletal muscle, and placenta.
-
數(shù)據(jù)庫鏈接:
Most popular with customers
-
-
YWHAB Recombinant Monoclonal Antibody
Applications: ELISA, WB, IHC, IF, FC
Species Reactivity: Human, Mouse, Rat
-
Phospho-YAP1 (S127) Recombinant Monoclonal Antibody
Applications: ELISA, WB, IHC
Species Reactivity: Human
-
-
-
-
-